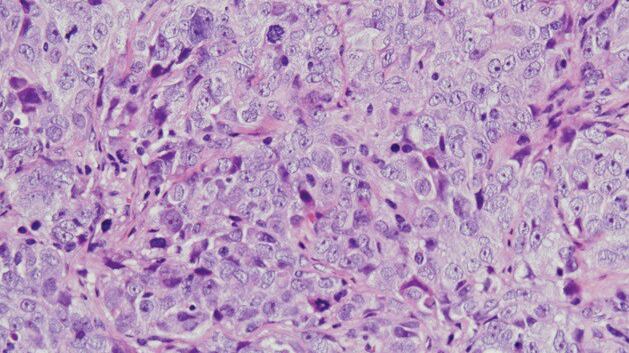

MADRID, 5 (EUROPA PRESS)
El cáncer de ovario es uno de los cánceres ginecológicos más mortales en las mujeres. Cada año se diagnostican en todo el mundo unos 300.000 nuevos casos y se producen unas 200.000 muertes. La mayoría de los cánceres de ovario son de origen epitelial y, de ellos, más del 70 por ciento se catalogan como tumores de ovario de alto grado y suelen diagnosticarse en un estadio avanzado, dado que no presentan síntomas ni signos específicos en su fase inicial. Estas circunstancias le confieren un mal pronóstico y exigen el desarrollo de nuevas estrategias terapéuticas para combatir la evolución de la enfermedad.
En este contexto, este estudio se ha centrado en la búsqueda de nuevas entidades moleculares implicadas en la progresión de los tumores epiteliales de ovario y ha evaluado la eficacia clínica de posibles terapias dirigidas a dichas moléculas. Para ello, este equipo de investigadores comenzó analizando, en diferentes líneas celulares de cáncer de ovario epitelial, el estado de activación de unas cuarenta proteínas que participan en varias rutas de señalización.
Esto llevó a la identificación de una proteína, denominada WNK1, que se encontraba anormalmente activa en las líneas celulares analizadas. Este resultado impulsó el análisis del estado de activación de esta proteína en tumores de pacientes diagnosticadas con diferentes tipos de cáncer de ovario en el Hospital Universitario de Salamanca, revelando que la activación anormal de WNK1 afectaba drásticamente a la supervivencia de las pacientes.
Otro hallazgo destacado de la investigación está relacionado con la vía de transducción de señales ERK1/2. Mediante este estudio se ha constatado que cuando se tratan las células de cáncer de ovario con Trametinib (un fármaco inhibidor de la activación de la vía de ERK1/2 y una nueva opción como terapia dirigida en el tratamiento de cáncer de ovario), la célula tumoral reacciona activando el eje de señalización de las proteínas WNK1-MEK5-ERK5, como una vía de escape para su supervivencia.
Como consecuencia de este proceso, disminuye la eficacia antitumoral de Trametinib. Un efecto indeseable que pudiera ser responsable de resistencias desarrolladas al tratamiento con inhibidores de la vía de ERK1/2. A este respecto, este estudio pone de manifiesto que la eficacia del tratamiento combinado de Trametinib con inhibidores de la vía de ERK5 es superior al tratamiento individual, advirtiendo de un posible refinamiento de la terapia con Trametinib teniendo en consideración la ruta WNK1-ERK5 en futuros regímenes de tratamiento de precisión del cáncer de ovario.
La investigación ha contado con la colaboración de los doctores Pandiella (Profesor del CSIC en el Centro de Investigación del Cáncer, y CIBERONC) y Ocaña (Hospital Clínico San Carlos-Madrid, y CIBERONC), así como del departamento de Anatomía Patológica del Hospital Universitario de Salamanca y del departamento de Cirugía de la Universidad de Dakota del Sur, de Estados Unidos. Este estudio ha sido posible gracias a la financiación aportada por el Instituto de Salud Carlos III y la Fundación CRIS contra el cáncer.